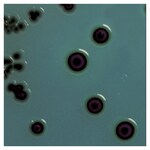
Culti-Loops&trade; 肠道沙门氏菌肠道亚种鼠伤寒血清型 ATCC&trade; 14028&trade;

Search
Thermo Scientific™
Culti-Loops™ 肠道沙门氏菌肠道亚种鼠伤寒血清型 ATCC™ 14028™
即用型质控微生物,推荐用于培养基、染色液、试剂和鉴定试剂盒的性能测试,也可用于评估细菌学程序。
| 货号 | 数量 |
|---|---|
| R4606000 | 5支接种环/包 |
货号 R4606000
价格(CNY)
-
数量:
5支接种环/包
Thermo Scientific™ Culti-Loops™ 是即用型质控微生物,推荐用于培养基、染色剂、试剂和鉴定试剂盒的性能测试,也可用于评估细菌学程序。
该接种环可溶于液体培养基、Culti-Loops 需氧菌套装中的再水化液(部件号 R4631000)或直接在适当的培养基上划线接种。
订购信息:
Culti-Loops 每支接种环单独密封在一个铝箔袋中,每个包装含 5 支接种环。
*ATCC Licensed Derivative Emblem、ATCC Licensed Derivative 文字商标和 ATCC 目录商标均为 ATCC™ 的商标,并根据授权使用。
规格
ATCC®14028TM*
描述肠沙门氏菌肠道亚种鼠伤寒血清型 ATCC™ 14028™
产品规格Culti-Loops
数量5支接种环/包
应变指示CDC 6516-60
产品类型Culti-Loops 质控微生物
靶标有机物类革兰氏阴性杆菌
测试类型定性 QC
Unit SizeEach